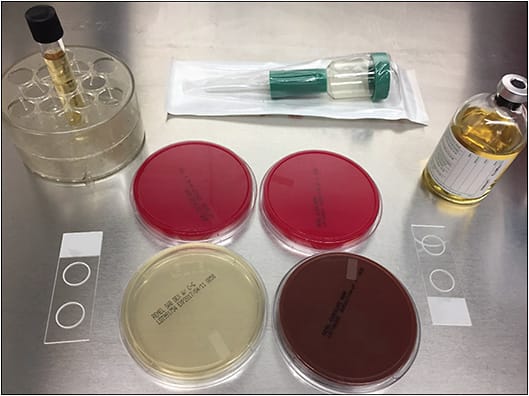
Figure 1. Various culture media used for vitreous sample in patients with endophthalmitis. IMAGE COURTESY OF HARRY FLYNN JR., MD

When was the last time your treatment of infectious endophthalmitis was changed based on the culture and staining results? An important principle in the management of infections caused by specific microorganisms is to establish, when possible, a microbiologic diagnosis. Isolation of the specific pathogen through procurement of a specimen in the site of the infection, followed by appropriate laboratory evaluation (staining and culture), preferably before the institution of antimicrobial therapy, is the foundation of this method.
However, microbiological diagnosis is often not available due to many factors, including negative cultures and stains, compounded by a lack of a local laboratory experienced in processing and examining vitreous specimens. Fortunately, in medicine, the microbiologic etiology can frequently be inferred from clinical presentation; therefore, the infection can be treated empirically. For example, no organisms are detected in up to 62% of cases of community-acquired pneumonia (CAP, commonly caused by Streptococcus pneumoniae, Haemophilus influenzae, and Mycoplasma pneumoniae).1 Community-acquired pneumonia can be treated empirically with a macrolide or (“respiratory”) fluoroquinolone (levofloxacin, moxifloxacin) antibiotic without performing specific diagnostic testing.2 Similarly, cellulitis, which can be associated with a negative culture in up to 70% of cases, can be successfully treated with antibacterial treatment of streptococci or staphylococci in the absence of a positive culture.3
Like CAP and cellulitis, endophthalmitis is often associated with negative cultures and stains. The landmark Endophthalmitis Vitrectomy Study (EVS), originally published in 1995, evaluated management of bacterial endophthalmitis occurring after cataract surgery.4,5 The results showed that vitreous fluid microbiologic culture results were positive only in 69% of patients. Aqueous humor is a less favorable medium for microbial proliferation compared with the vitreous, so the rates of positive aqueous humor culture were even lower: Only 27% of aqueous specimens were culture positive in EVS.
The use of polymerase chain reaction (PCR) to identify organisms in the absence of culture positivity does not appear to solve the problem. Although 1 study showed PCR techniques allowed a microbiological diagnosis in 25% of cases that were reported as culture-negative,6 another study failed to show 16S ribosomal (prokaryotic, bacterial) RNA in any culture-negative sample.7
Since the conclusion of the EVS, which focused on endophthalmitis following cataract surgery, the huge increase in intravitreal injections has created a category of postprocedure infection that did not exist in 1995.8 Unfortunately, the issue of low culture positivity continues. A retrospective study of 133 endophthalmitis cases treated at a tertiary care institution between 2009 and 2018 from a variety of related predispositions (including intravitreal injection, trabeculectomy, partial- or full-thickness corneal transplantation, infectious keratitis, open-globe injury, glaucoma drainage device placement, pars plana vitrectomy, and endogenous source) demonstrated only 45% culture-positive results.9 A retrospective study evaluating endophthalmitis outcomes from a variety of sources at a tertiary care center in New Zealand between 2006 and 2018 demonstrated positive vitreous samples in 45%, aqueous samples in 32%, and vitrectomy culture positivity in only 37% of cases.10 Regarding endogenous endophthalmitis, a recent study demonstrated intraocular culture positivity of only 28.6%, and this decreased to 0% after the initiation of systemic antibiotics.11
Fortunately, just as in CAP and cellulitis, armed with existing epidemiologic data, we can usually predict likely etiologic organisms based on clinical scenario. The EVS results showed that in endophthalmitis following cataract surgery, 94.1% of culture-positive endophthalmitis cases involved gram-positive bacteria: 70% of isolates were gram-positive, coagulase-negative staphylococci (CoNS), 9.9% were Staphylococcus aureus, 9.0% were Streptococcus species, 2.2% were Enterococcus species, and 3% were other gram-positive species. Gram-negative species were involved in 5.9% of cases.4,5 Endophthalmitis following glaucoma drainage device surgery has the same microbiologic spectrum as in cases following cataract surgery.12 Postinjection endophthalmitis (PIE) is also usually caused by CoNS, most often Staphylococcus epidermidis.13 Endophthalmitis following glaucoma filtration surgery with trabeculectomy is most commonly associated with streptococci in acute cases and streptococci and H influenzae in delayed cases.14 Posttraumatic endophthalmitis is mostly due to gram-positive organisms, with a high incidence of Bacillus infections in soil-contaminated wounds or cases associated with intraocular foreign bodies.15 Fungal organisms account for the majority of endogenous endophthalmitis.11,16
For decades, the use of standard empiric treatment with intravitreal vancomycin (to treat typical gram-positive pathogens, including CoNS and methicillin-resistant S aureus) and ceftazidime (to treat gram-negative bacteria and Streptococcus) has successfully treated nonendogenous endophthalmitis in the vast majority of cases; the efficacy of the antibiotics is enhanced by the fact that the concentration of intravitreal antibiotics is typically 50 times higher than the minimal inhibitory concentration for most bacteria.17 Intravitreal amphotericin is considered in chronic and traumatic cases where fungus is suspected; in posttraumatic endophthalmitis, Bacillus species are most often resistant to penicillins and cephalosporins due to beta-lactamase, but are sensitive to vancomycin.18
Given the high percentage of negative cultures, the excellent response rate to intravitreal vancomycin and ceftazidime (now over several decades), a fair question to ask (which on its face appears heretical) is should we attempt to obtain these specimens routinely when we are attempting to manage endophthalmitis in a nonsurgical manner (especially if we do not have an experienced local laboratory)? What is the “number needed to culture” to change our management once?
A recent study showed that culture results were used to influence retreatment of endophthalmitis less than 50% of the time by 78% of the respondents.19 Ophthalmologists were most likely to proceed to vitrectomy management of endophthalmitis based on clinical worsening within 48 hours of intravitreal antibiotic treatment rather than using culture results. It is difficult to rely on a clinical test to guide real-time clinical decisions when the test shows negative results so frequently. Is the risk–benefit ratio of 2 additional interventions (vitreous and anterior-chamber paracentesis) justified, given the additional risk of the procedures and discomfort (especially in an eye that is already inflamed)? Will the additional information bring better results (especially given the high number of negative cultures)? Should we only consider obtaining a culture if we are not seeing a clinical response after treatment? We are fortunate to have commentary regarding this issue from Harry Flynn Jr., MD, and Sunir J. Garg, MD.
Harry Flynn Jr., MD
Bascom Palmer Eye Institute, University of Miami Health System
This question has been debated for decades. Yes, it is true that most acute-onset postoperative endophthalmitis patients can be treated empirically. As previously discussed, the use of a vitreous tap prior to antibiotic injection is a common standard in retina practices. Larger hospitals and university-based referral centers have microbiology departments capable of processing and reporting culture outcomes efficiently. By contrast, individual practitioners working in satellite offices may not have access to efficient handling of a culture specimen. In this setting of a private office, use of a culture plate or blood culture bottle may be a practical option for the vitreous specimen.
It is correct that large case series and retrospective reviews have reported the most frequent causative organisms in various categories of endophthalmitis. It is also well known that gram-positive organisms are most commonly identified in acute-onset endophthalmitis following cataract surgery, as well as after most recent anterior-segment surgery. In EVS, 94% of confirmed intraocular cultures were identified as gram-positive organisms, whereas only 6% were gram-negative organisms.4,5 It is important to recognize that suspected fungal cases and the cases that occurred ≥6 weeks of the cataract surgery were excluded from EVS. Even with this knowledge, we continue to see unusual microbial causes and the presence of a positive culture will help to guide continuing management during the follow-up.20,21
In other categories of endophthalmitis following anterior-segment surgery (eg, glaucoma filtering bleb, glaucoma tube placement, penetrating keratoplasty, Descemet stripping endothelial keratoplasty), gram-positive organisms including streptococci are the most frequent organisms.22-24 With delayed-onset endophthalmitis occurring more than 6 weeks after cataract surgery, a variety of causes have been identified: Propionibacterium acnes, fungi, and less virulent gram-negative organisms. Because of this spectrum of causes, it is important to obtain cultures in order to avoid prolonged treatment with an incorrect antimicrobial (Figure 1). If the intraocular lens and the capsular bag are being removed, half of the specimen can be submitted for microbiology and the other half can be submitted to pathology for a higher chance of identifying the causative organisms.
In cases of endogenous endophthalmitis, patients often present with focal lesions in the posterior pole or in the posterior vitreous.25,26 The use of a vitreous tap for culture often does not yield a positive result. Many of these patients already have a positive blood culture or a positive distal site culture, which allows appropriate antimicrobial therapy to be administered.
Obtaining a vitreous sample for culture is challenging. Pars plana vitrectomy is the ideal way to obtain vitreous samples. Processing a vitrectomy specimen using a membrane-filtering system will allow concentration of the organisms and give a much higher rate of identification.27 Likewise, PCR can provide additional data for identification in cases with negative results on standard culture media. An alternative technique, which is now commonly employed, is the use of a pars plana trocar to obtain the specimen and to allow easier antimicrobial administration.28,29 This procedure can be performed under subconjunctival anesthesia and is generally well tolerated by patients.
Medicolegal issues continue to arise in cases in which intraocular cultures were not obtained. This scenario is more problematic in more severe cases where organisms were not identified and the eye continues to worsen without knowledge of the causative organism.30-32 In addition, in cases with resistant species causing endophthalmitis, it is important to have a culture specimen that can be tested for various antimicrobials and guide the treatment.31 In one particular patient, this issue was at the center of the allegation by the plaintiff against the treating physician, who was working out of a satellite office.
Vitreous cultures continue to be an important part of endophthalmitis management. This is especially true in cases of severe acute-onset postoperative endophthalmitis, but it may be less important in endogenous cases.
Sunir J. Garg, MD
Wills Eye Hospital, Thomas Jefferson University
Early in medical school, we were indoctrinated on the importance of obtaining culture results for any type of infection. If you didn’t know the results on rounds, you would get the look of death from the senior resident, a poor grade, and you would certainly hear the sound of your dreams of ophthalmology residency going down the drain. Partly due to a desire for diagnostic precision, as well as a need to avoid using antibiotics improperly as well as unnecessarily, we traditionally like to know the organism that we are treating so that we can apply the appropriate antimicrobial therapy.
Postprocedure endophthalmitis often is different from other systemic infections. As established by EVS, immediate treatment is important. Fortunately, the vast majority of organisms associated with postprocedure endophthalmitis are bacteria such as coagulase-negative staphylococci, S aureus, Streptococcus, and Enterococcus. Only a small percentage are from other, less common organisms. As such, traditional antibiotic choices offer broad coverage for the majority of organisms implicated, and the practical utility of cultures is questionable.
Is the risk–benefit ratio of 2 additional interventions justified, given the additional risk of the procedures and discomfort? We routinely attempt to obtain a vitreous culture whenever we know that it will be processed appropriately and promptly. When we are at the main Wills Eye Hospital, we send the specimens for culture. If we are unable to obtain a successful vitreous tap, we perform anterior-chamber paracentesis. However, this is primarily for volume. Each antibiotic injection takes up 0.1 mL, so the combined 0.2 mL is more than the eye can handle, therefore we need to lower the intraocular pressure. If the vitreous tap is successful, it enables us to send for culture as well as lower the intraocular pressure. Otherwise, we will send the anterior-chamber specimen to culture; however, the yield is low.
Our group published 2 studies on whether better results are obtained with the additional information. One study examined the role of endophthalmitis after cataract surgery, specifically regarding changes in management based on microbial cultures of 111 eyes from 111 patients.33 Of the 111 eyes, 51% were culture positive. All patients had immediate treatment of endophthalmitis with intraocular antibiotics. A change in the management of endophthalmitis occurred after vitreous culture in 9 of the 111 eyes (8%) including 6 of the 57 (11%) culture-positive eyes, whereas a change occurred with 3 of the 54 (6%) culture-negative eyes (P=.49). Clinical management in the culture-positive eyes was due to declining vision, deteriorating clinical exam, and, in one case, a retinal detachment. In the culture-negative group, 2 eyes had a change in clinical management due to worsening clinical exam and in 1 eye it was due to deteriorating vision. Importantly, none of these management changes were due to culture results.
We do know, however, that there is some prognostic significance to culture results. As a rule of thumb, aggressive organisms such as Streptococcus will often have a worse visual acuity outcome than organisms such as S epidermidis. This can help frame the conversation with the patient. However, in my clinical experience, often the clinical exam on presentation will give you some sense of the virulence of the organism, thereby further reducing the critical importance of cultures.
A similar study examined cases of endophthalmitis after anti-VEGF injection.34 Sixty cases of postinjection endophthalmitis were reviewed. Of these, 18 were culture positive (our group as well as others have published on this lower rate). During follow-up, 6 (10%) eyes had a change in management. A change in clinical management was initiated in 3 of 18 (17%) culture-positive cases compared with 3 of 42 (7%) culture-negative cases (P=.357). Similar to the postcataract study, management changes were based on changes in vision or on worsening of clinical exam, and not on culture results.
I would recommend that retina specialists obtain a culture whenever it is reasonably possible to do so and when the laboratory will be able to handle the specimen appropriately. We need to remove volume from the eye to perform the antibiotic injection anyway, so sending it for culture rather than discarding it has a role. Culture results may be helpful for quality control as well as research purposes.7,35 Patients also sometimes like to learn what bacteria caused the infection. RP
REFERENCES
- Jain S, Self WH, Wunderink RG, et al; CDC EPIC Study Team. Community-acquired pneumonia requiring hospitalization among U.S. adults. N Engl J Med. 2015 Jul 30;373(5):415-427. doi:10.1056/NEJMoa1500245
- Mandell LA, Wunderink RG, Anzueto A, et al. Infectious Diseases Society of America/American Thoracic Society consensus guidelines on the management of community-acquired pneumonia in adults. Clin Infect Dis. 2007;44(suppl 2):S27-S72.
- Eron LJ. Lipsky BA. Use of cultures in cellulitis: when, how, and why? Eur J Clin Microbiol Infect Dis. 2006;25:615-617. doi:10.1007/s10096-006-0187-y
- Endophthalmitis Vitrectomy Study Group. Results of the endophthalmitis vitrectomy study. A randomized trial of immediate vitrectomy and of intravenous antibiotics for the treatment of postoperative bacterial endophthalmitis. Arch Ophthalmol. 1995;113:1479-1496.
- Flynn HW Jr, Scott IU. Legacy of the endophthalmitis vitrectomy study. Arch Ophthalmol. 2008;126(4):559-561. doi: 10.1001/archopht.126.4.559
- Chiquet C, Cornut PL, Benito Y, et al. Eubacterial PCR for bacterial detection and identification in 100 acute postcataract surgery endophthalmitis. Invest Ophthalmol Vis Sci. 2008;49:1971-1978. doi:10.1167/iovs.07-1377
- Lee AY, Akileswaran L, Tibbetts MD, Garg SJ, Van Gelder RN. Identification of torque teno virus in culture-negative endophthalmitis by representational deep DNA sequencing. Ophthalmology. 2015;122(3):524-530. doi:10.1016/j.ophtha.2014.09.001
- Shah CP, Garg SJ, Vander JF, Brown GC, Kaiser RS, Haller JA; Post-Injection Endophthalmitis (PIE) Study Team. Outcomes and risk factors associated with endophthalmitis after intravitreal injection of anti-vascular endothelial growth factor agents. Ophthalmology. 2011 Oct;118(10):2028-2034. doi: 10.1016/j.ophtha.2011.02.034
- Feng HL, Robbins CB, Fekrat S. A nine-year analysis of practice patterns, microbiologic yield, and clinical outcomes in cases of presumed infectious endophthalmitis. Ophthalmol Retina. 2020;4(6):555-559. doi: 10.1016/j.oret.2020.03.009
- Bhikoo R, Wang N, Welch S, Polkinghorne P, Niederer R. Factors associated with positive microbial culture in patients with endophthalmitis based on clinical presentation and multimodal intraocular sampling. Asia Pac J Ophthalmol (Phila). 2020;9(1):4-8. doi:10.1097/APO.0000000000000263
- Regan KA, Radhakrishnan NS, Hammer JD et al. Endogenous endophthalmitis: yield of the diagnostic evaluation. BMC Ophthalmol. 2020;20:138.
- Wentzloff JN, Grosskreutz CL, Pasquale LR, Walton DS, Chen TC. Endophthalmitis after glaucoma drainage implant surgery. Int Ophthalmol Clin. 2007;47(2):109-115. doi:10.1097/IIO.0b013e318037766a
- Dossarps D, Bron AM, Koehrer P, Aho-Glélé LS, Creuzot-Garcher C; FRCR net (FRenCh Retina specialists net). Endophthalmitis after intravitreal injections: incidence, presentation, management, and visual outcome. Am J Ophthalmol. 2015;160(1):17-25.e1. doi:10.1016/j.ajo.2015.04.013
- Lemley CA, Han DP. Endophthalmitis: a review of current evaluation and management. Retina. 2007;27(6):662-680. doi:10.1097/IAE.0b013e3180323f96. Erratum in: Retina. 2007;27(7).
- Bhagat N, Nagori S, Zarbin M. Post-traumatic Infectious Endophthalmitis. Surv Ophthalmol. 2011;56(3):214-251. doi:10.1016/j.survophthal.2010.09.002
- Schiedler V, Scott IU, Flynn HW Jr, Davis JL, Benz MS, Miller D. Culture-proven endogenous endophthalmitis: clinical features and visual acuity outcomes. Am J Ophthalmol. 2004;137(4):725-731. doi:10.1016/j.ajo.2003.11.013
- Gan IM, van Dissel JT, Beekhuis WH, Swart W, van Meurs JC. Intravitreal vancomycin and gentamicin concentrations in patients with postoperative endophthalmitis. Br J Ophthalmol. 2001;85(11):1289-1293. doi:10.1136/bjo.85.11.1289
- Davey RT Jr, Tauber WB. Posttraumatic endophthalmitis: the emerging role of Bacillus cereus infection. Rev Infect Dis. 1987;9(1):110-23. doi:10.1093/clinids/9.1.110
- Fliney GD, Pecen PE, Cathcart JN, Palestine AG. Trends in treatment strategies for suspected bacterial endophthalmitis. Graefes Arch Clin Exp Ophthalmol. 2018;256(4):833-838. doi:10.1007/s00417-018-3910-3
- Yannuzzi NA, Si N, Relhan N, Kuriyan AE, Albini TA, Berrocal AM, Davis JL, Smiddy WE, Townsend J, Miller D, Flynn HW Jr. endophthalmitis after clear corneal cataract surgery: outcomes over two decades. Am J Ophthalmol. 2017;174:155-159. doi:10.1016/j.ajo.2016.11.006
- Pathengay A, Flynn HW Jr, Isom RF, Miller D. Endophthalmitis outbreaks following cataract surgery: causative organisms, etiologies, and visual acuity outcomes. J Cataract Refract Surg. 2012;38(7):1278-1282. doi:10.1016/j.jcrs.2012.04.021
- Jacobs DJ, Leng T, Flynn HW Jr, Shi W, Miller D, Gedde SJ. Delayed-onset bleb-associated endophthalmitis: presentation and outcome by culture result. Clin Ophthalmol. 2011;5:739-744. doi:10.2147/OPTH.S17975
- Ahmed Y, Pathengay A, Flynn HW Jr, Isom R. Delayed-onset endophthalmitis associated with Ex-PRESS mini glaucoma shunt. Ophthalmic Surg Lasers Imaging. 2012;43 Online:e62-e63. doi:10.3928/15428877-20120705-01
- Shirodkar AR, Pathengay A, Flynn HW Jr, et al. Delayed- versus acute-onset endophthalmitis after cataract surgery. Am J Ophthalmol. 2012;153(3):391-398.e2. doi:10.1016/j.ajo.2011.08.029
- Sridhar J, Flynn HW Jr, Kuriyan AE, Miller D, Albini T. Endogenous fungal endophthalmitis: risk factors, clinical features, and treatment outcomes in mold and yeast infections. J Ophthalmic Inflamm Infect. 2013;3(1):60. doi:10.1186/1869-5760-3-60
- Fan KC, Russell JF, Miller D, Flynn HW Jr. In vitro susceptibilities of vitreous candida endophthalmitis isolates to newer and traditional antifungal agents. Ophthalmic Surg Lasers Imaging Retina. 2019;50(5):S13-S17. doi:10.3928/23258160-20190108-04
- Rachitskaya AV, Flynn HW Jr, Wong J, Kuriyan AE, Miller D. A 10-year study of membrane filter system versus blood culture bottles in culturing vitrectomy cassette vitreous in infectious endophthalmitis. Am J Ophthalmol. 2013;156(2):349-354.e2. doi:10.1016/j.ajo.2013.03.040
- Chan A, Leng T, Moshfeghi DM. Cannula-based 25-gauge vitreous tap and injection: a new surgical technique. Retina. 2012;32(5):1021-1022. doi:10.1097/IAE.0b013e318248e6ba. Erratum in: Retina. 2012;32(8):1700.
- Vahedi S, Murtaza KA, Dollin M, Maguire JI. 25-gauge trocar cannula for acute endophthalmitis-related in-office vitreous tap and injection: patient comfort and physician ease of use. Retina. 2017;37(4):657-661. doi:10.1097/IAE.0000000000001201
- Leung EH, Kuriyan AE, Flynn HW Jr, Miller D, Huang LC. Persistently vitreous culture-positive exogenous bacterial endophthalmitis. Am J Ophthalmol. 2016;165:16-22. doi:10.1016/j.ajo.2016.02.017
- Relhan N, Pathengay A, Schwartz SG, Flynn HW Jr. Emerging worldwide antimicrobial resistance, antibiotic stewardship and alternative intravitreal agents for the treatment of endophthalmitis. Retina. 2017;37(5):811-818. doi:10.1097/IAE.0000000000001603
- Chang VS, Schwartz SG, Davis JL, Flynn HW Jr. Endophthalmitis following cataract surgery and intracameral antibiotic: Moxifloxacin resistant Staphylococcus epidermidis. Am J Ophthalmol Case Rep. 2018;13:127-130. doi:10.1016/j.ajoc.2018.12.003
- Patel SN, Storey PP, Levin H, et al. Endophthalmitis after cataract surgery: changes in management based on microbiologic cultures. Ophthalmol Retina. 2020;S2468-S6530(20)30256-6. doi:10.1016/j.oret.2020.06.028
- Patel SN, Storey PP, Pancholy M, et al. Changes in management based on vitreous culture in endophthalmitis after intravitreal anti-vascular endothelial growth factor injection. Am J Ophthalmol. 2019;207:224-231. doi:10.1016/j.ajo.2019.06.008
- Lee CS, Hong B, Kasi SK, et al; Endophthalmitis Study Group. Prognostic utility of whole-genome sequencing and polymerase chain reaction tests of ocular fluids in postprocedural endophthalmitis. Am J Ophthalmol. 2020;217:325-334. doi:10.1016/j.ajo.2020.03.008








